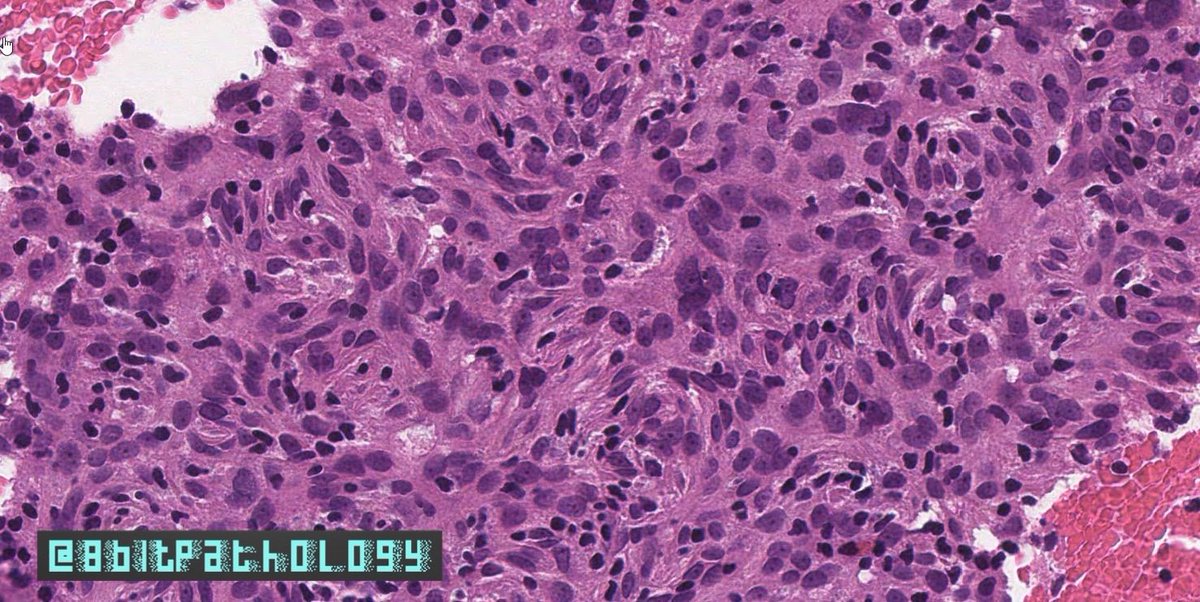
8bitPathology's tweet image. Follicular Dendritic Cell Sarcoma

📚adults (mean 50 yrs)

🔬Whorling prolif of syncytial cells w/ abundant pink cytoplasm
 📍Uniform ovoid nuclei w/ fine chromatin, distinct nucleoli, +/- focal atypia
 📍Lymphs peppered throughout

#8BitPath #HemePath #BSTPath
#ASCP40UnderForty

#8bitpath search results
Follicular Dendritic Cell Sarcoma 📚adults (mean 50 yrs) 🔬Whorling prolif of syncytial cells w/ abundant pink cytoplasm 📍Uniform ovoid nuclei w/ fine chromatin, distinct nucleoli, +/- focal atypia 📍Lymphs peppered throughout #8BitPath #HemePath #BSTPath #ASCP40UnderForty



#TwitterPath, I’m excited to announce my new Educational Project: @8bitPathology I’ll be posting cases, unknowns, and #pathtips; no/few retweets or dialogue. Why #8bitPath? Because I love #pathology, & I like old-school arcade #pixelart👾 Consider a follow! #ASCP40UnderForty

Spitting image right? 😆 My first foray into #pixelart. If you liked #DailyDx, please consider following my new project @8bitPathology! (and keep following @UmichPath, they are fantastic!) #8bitPath #8bitPathology #ASCP40UnderForty


Spitting image right? 😆 My first foray into #pixelart. If you liked #DailyDx, please consider following my new project @8bitPathology! (and keep following @UmichPath, they are fantastic!) #8bitPath #8bitPathology #ASCP40UnderForty


#TwitterPath, I’m excited to announce my new Educational Project: @8bitPathology I’ll be posting cases, unknowns, and #pathtips; no/few retweets or dialogue. Why #8bitPath? Because I love #pathology, & I like old-school arcade #pixelart👾 Consider a follow! #ASCP40UnderForty

Follicular Dendritic Cell Sarcoma 📚adults (mean 50 yrs) 🔬Whorling prolif of syncytial cells w/ abundant pink cytoplasm 📍Uniform ovoid nuclei w/ fine chromatin, distinct nucleoli, +/- focal atypia 📍Lymphs peppered throughout #8BitPath #HemePath #BSTPath #ASCP40UnderForty



#TwitterPath, I’m excited to announce my new Educational Project: @8bitPathology I’ll be posting cases, unknowns, and #pathtips; no/few retweets or dialogue. Why #8bitPath? Because I love #pathology, & I like old-school arcade #pixelart👾 Consider a follow! #ASCP40UnderForty

Follicular Dendritic Cell Sarcoma 📚adults (mean 50 yrs) 🔬Whorling prolif of syncytial cells w/ abundant pink cytoplasm 📍Uniform ovoid nuclei w/ fine chromatin, distinct nucleoli, +/- focal atypia 📍Lymphs peppered throughout #8BitPath #HemePath #BSTPath #ASCP40UnderForty

Spitting image right? 😆 My first foray into #pixelart. If you liked #DailyDx, please consider following my new project @8bitPathology! (and keep following @UmichPath, they are fantastic!) #8bitPath #8bitPathology #ASCP40UnderForty


Something went wrong.
Something went wrong.
United States Trends
- 1. No Kings N/A
- 2. No Kings N/A
- 3. CB Bucknor N/A
- 4. #UFCSeattle N/A
- 5. #USMNT N/A
- 6. Yanez N/A
- 7. #ENGENES_MADE_ENHYPEN_7 N/A
- 8. Kevin Harlan N/A
- 9. Belgium N/A
- 10. Nick Cannon N/A
- 11. Moses Itauma N/A
- 12. Sonny Gray N/A
- 13. Keith Peterson N/A
- 14. Robert Garcia N/A
- 15. Casey O'Neill N/A
- 16. Devin Williams N/A
- 17. Simon N/A
- 18. Angel Hernandez N/A
- 19. Ream N/A
- 20. Fang Fang N/A


